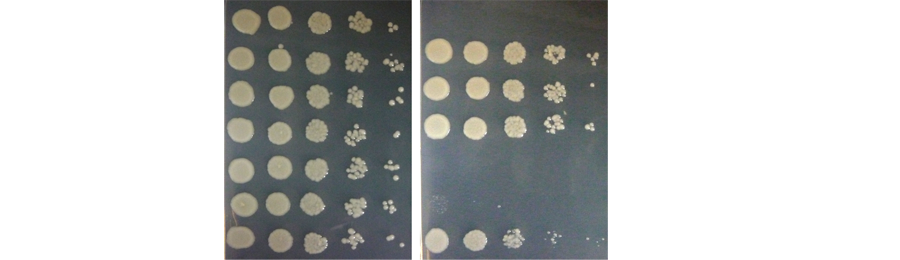

PostDoc Position in Translation Control is available apply now
Protein biosynthesis is now-a-days increasingly linked to inherited diseases, cancer, diabetes, obesity, embryonic development, learning and memory formation. Numerous antibiotics and toxins are known to target the translation apparatus. In order to translate the knowledge acquired into "translational research" we need an in-depth understanding of mechanism of protein biosynthesis.
Our research interest is to understand the regulation and mechanism of open reading frame selection in yeast model using range of molecular genetics, biochemical and biophysical techniques.